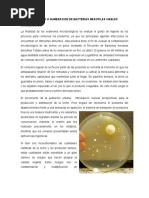

0% encontró este documento útil (0 votos)
58 vistas45 páginasPresentacion
Este documento describe la microbiología de la leche y métodos para determinar la calidad microbiológica. Explica que la leche es un medio propicio para el crecimiento microbiano debido a su composición. Detalla pruebas indirectas como el sedimento y directas como el recuento estándar en placa para medir la carga microbiana. Además, clasifica los principales tipos de microorganismos que pueden contaminar la leche como bacterias lácticas y coliformes.
Cargado por
Milena GuerridosDerechos de autor
© © All Rights Reserved
Nos tomamos en serio los derechos de los contenidos. Si sospechas que se trata de tu contenido, reclámalo aquí.
Formatos disponibles
Descarga como PDF, TXT o lee en línea desde Scribd
0% encontró este documento útil (0 votos)
58 vistas45 páginasPresentacion
Este documento describe la microbiología de la leche y métodos para determinar la calidad microbiológica. Explica que la leche es un medio propicio para el crecimiento microbiano debido a su composición. Detalla pruebas indirectas como el sedimento y directas como el recuento estándar en placa para medir la carga microbiana. Además, clasifica los principales tipos de microorganismos que pueden contaminar la leche como bacterias lácticas y coliformes.
Cargado por
Milena GuerridosDerechos de autor
© © All Rights Reserved
Nos tomamos en serio los derechos de los contenidos. Si sospechas que se trata de tu contenido, reclámalo aquí.
Formatos disponibles
Descarga como PDF, TXT o lee en línea desde Scribd